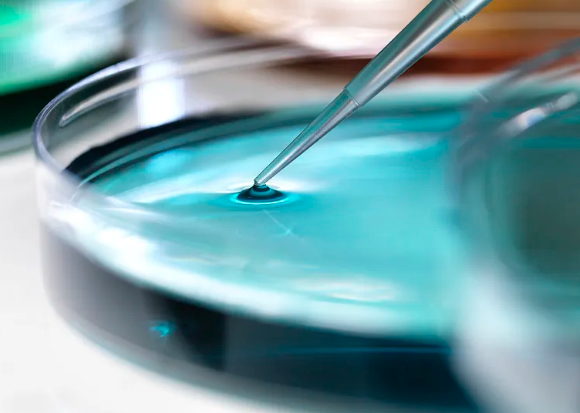
干細胞保持多久有效果附注意事項(圖1) image.png

干細(xì)胞保持多久有效果附注意事項
2024-09-04 14:17:37 來源: 小編 咨詢醫(yī)生
干細(xì)胞是生物醫(yī)學(xué)領(lǐng)域一個備受矚目的研究對象,因其獨特的自我更新和多向分化能力而被廣泛應(yīng)用于再生醫(yī)學(xué)、細(xì)胞治療以及抗衰老研究等方面。然而,隨著技術(shù)的發(fā)展,很多人都在關(guān)注干細(xì)胞存儲和應(yīng)用的有效性。那么,干細(xì)胞的有效期到底有多長呢?
一、干細(xì)胞的類型及其有效期
1.胚胎干細(xì)胞(ESCs)
胚胎干細(xì)胞是從早期胚胎中提取的,這些細(xì)胞具有無限的增殖能力和多種分化潛能。在適當(dāng)?shù)呐囵B(yǎng)條件下,胚胎干細(xì)胞可以長期存活并保持其干細(xì)胞特性,一般來說,它們在實驗室條件下可以維持?jǐn)?shù)月到數(shù)年的有效性。
2.誘導(dǎo)性多能干細(xì)胞(iPSCs)
誘導(dǎo)性多能干細(xì)胞是通過重編程成人體細(xì)胞所得到的,這些細(xì)胞同樣能夠保持多能性。在冷凍條件下,iPSCs可以在196℃的液氮中保存,理論上能保持有效性數(shù)十年,甚至更久。
3.成體干細(xì)胞(ASCs)
成體干細(xì)胞存在于特定的組織中,如骨髓、脂肪和神經(jīng)組織等。它們的生長和增殖能力相對有限,若不進(jìn)行合適的存儲和處理,可能會在短時間內(nèi)喪失活性。因此,成體干細(xì)胞的有效期較短,一般建議在取樣后數(shù)周內(nèi)進(jìn)行應(yīng)用。
二、干細(xì)胞的保存方式
有效的干細(xì)胞保存方式是確保其長期活性和功能的關(guān)鍵。常見的保存方法包括:
1.冷凍保存
干細(xì)胞在液氮中以低溫(196℃)冷凍保存,能夠有效減緩細(xì)胞代謝,達(dá)到長期存儲的目的。冷凍保存前,通常需要使用冷凍保護(hù)劑來減少冰晶對細(xì)胞的損傷。
2.細(xì)胞培養(yǎng)
對于體外培養(yǎng)的干細(xì)胞,必須保持適宜的生長條件,包括溫度、pH值和營養(yǎng)物質(zhì)供給等,以確保細(xì)胞的活性和增殖能力。
三、干細(xì)胞應(yīng)用的注意事項
1.選擇正規(guī)機(jī)構(gòu)
進(jìn)行干細(xì)胞治療時,一定要選擇具備相應(yīng)資質(zhì)的醫(yī)療機(jī)構(gòu),以確保操作的安全性和有效性。
2.風(fēng)險評估
患者在接受干細(xì)胞治療前需進(jìn)行全面的健康評估,了解相關(guān)的風(fēng)險和可能出現(xiàn)的副作用,以制定個性化的治療方案。
3.關(guān)注法律法規(guī)
不同國家對干細(xì)胞研究和應(yīng)用的法律法規(guī)存在差異,了解并遵守相關(guān)法律法規(guī)至關(guān)重要。
4.長期跟蹤
干細(xì)胞治療后,患者應(yīng)定期進(jìn)行醫(yī)學(xué)檢查,以監(jiān)測治療效果和健康狀況,及時應(yīng)對可能的問題。
結(jié)論
干細(xì)胞在科學(xué)研究和臨床應(yīng)用中展現(xiàn)出廣闊的前景,其保持的有效期與細(xì)胞類型、存儲條件以及使用方式密切相關(guān)。通過對干細(xì)胞的合理保存和應(yīng)用,不僅能夠提高治療效果,還能夠降低不必要的風(fēng)險。希望本文能為您在了解干細(xì)胞的有效性方面提供一定的指導(dǎo)。
文章來源:https://www.2008eshop.cn/ganxibao/37374.html
- 2024-11-08干細(xì)胞的用途有哪些呢,在臨床治療中的具體應(yīng)用
- 2024-07-24自體干細(xì)胞抗衰多少錢,自體干細(xì)胞抗衰效果好嗎
- 2024-10-12干細(xì)胞移植后幾天能見效?哪些因素影響恢復(fù)?
- 2024-10-30回輸干細(xì)胞的好處有哪些?如何選擇正規(guī)機(jī)構(gòu)?
- 2024-10-11干細(xì)胞培植皮膚技術(shù)成熟嗎?效果可以持續(xù)多久?
- 2024-11-02骨髓捐獻(xiàn)造血干細(xì)胞如何申請?捐獻(xiàn)流程是怎樣的?
- 2024-09-26干細(xì)胞采集作用是什么,干細(xì)胞的用途
- 2024-09-13人造干細(xì)胞注射費用,注射干細(xì)胞需要多少錢
- 2024-09-13山東莒縣捐贈干細(xì)胞機(jī)構(gòu)有哪些,內(nèi)附名單表
- 2024-09-21干細(xì)胞體內(nèi)代謝過程,代謝周期都是多少天
- 2024-10-08植物干細(xì)胞增殖調(diào)控機(jī)構(gòu)如何運作?有哪些研究成果?
- 2024-09-11國內(nèi)比較好的干細(xì)胞醫(yī)院排名榜最新
- 2024-09-06干細(xì)胞抗衰老療法需要多少錢
- 2024-10-04如何深入理解干細(xì)胞技術(shù)?存在哪些應(yīng)用誤區(qū)?
- 2024-08-04干細(xì)胞與抗衰老,干細(xì)胞抗衰老是不是騙局
- 2024-09-03溫莎之謎干細(xì)胞抗衰分析,干細(xì)胞護(hù)膚品的作用和功效
- 2024-09-17干細(xì)胞移植后能生育嗎,對生育影響大嗎
- 2024-09-04靶向干細(xì)胞費用高嗎,一個療程多少錢
